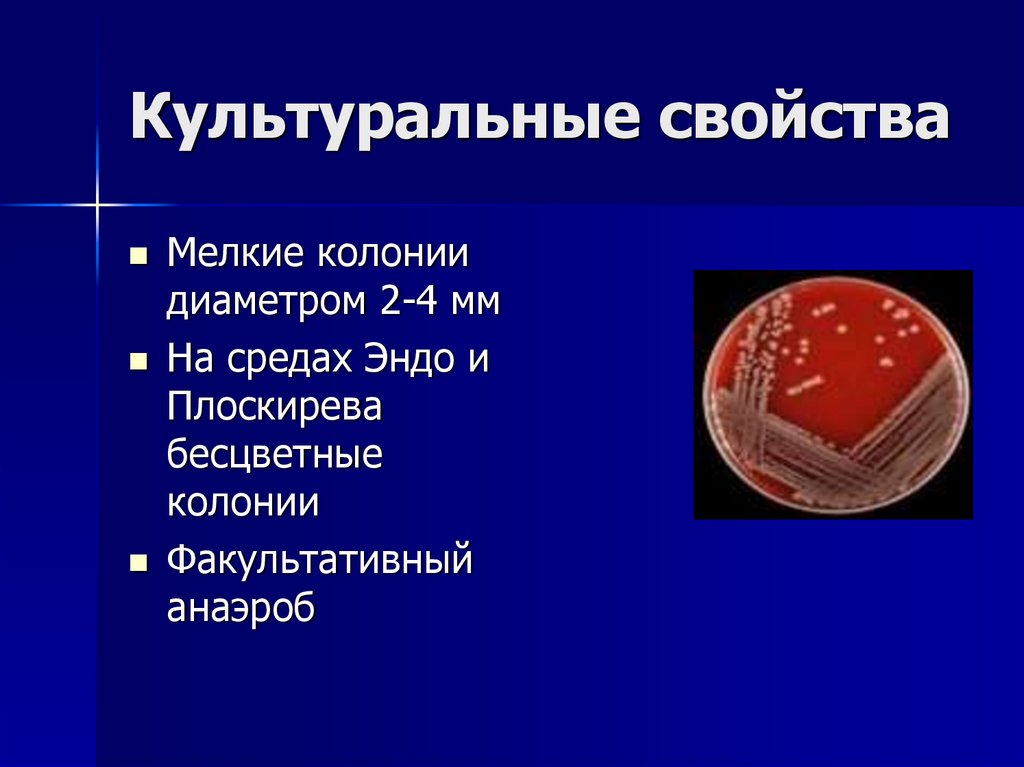
Культуральные свойства
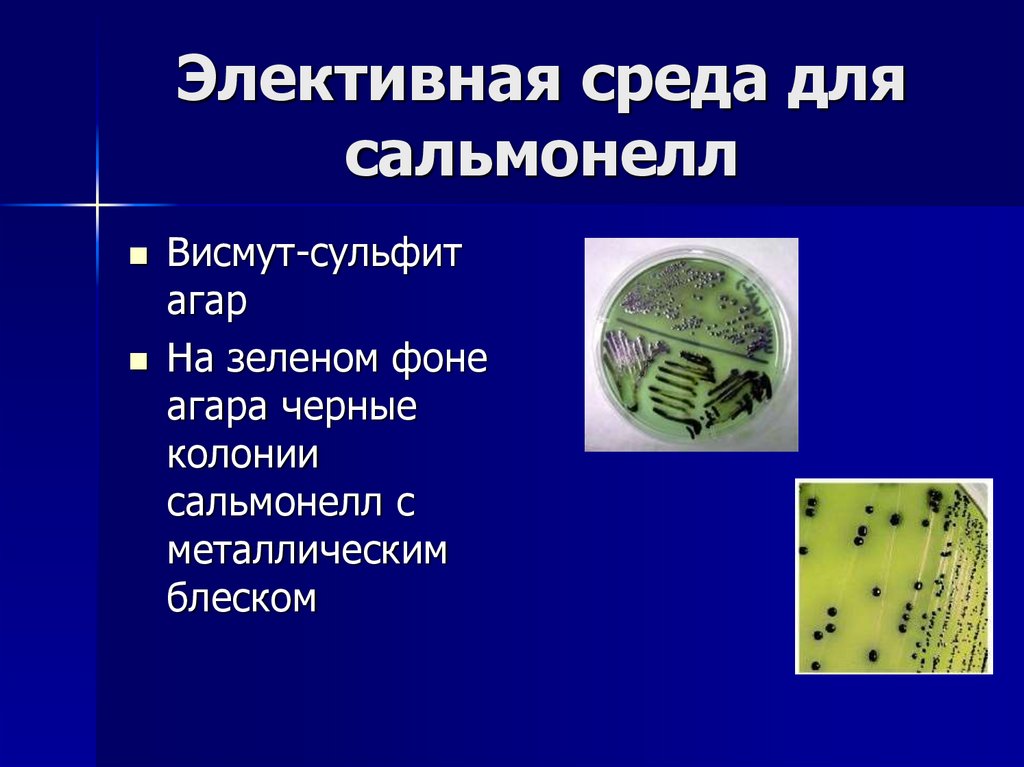
Элективная среда для сальмонелл

Похожие презентации:
Сальмонеллезы н 2
1. СЕМЕЙСТВО ЭНТЕРОБАКТЕРИЙ Род Сальмонеллы
Лектор: зав. кафедрой, доктормедицинских наук, профессор
Примак Татьяна Дмитриевна
2. Экологическая классификация инфекций
1.2.
3.
Антропонозы: основной резервуар –
человек. Например: дизентерия
Зоонозы: основной резервуар инфекции
– животные. Например: сальмонеллез
Сапронозы: основной резервуар –
окружающая среда.
Например: газовая гангрена.
Смешанные формы: Антропозоонозы
3. Причины актуальности ОКИ
Рост инфекционной заболеваемости вмире, в т. ч. и кишечными инфекциями
Резистентность возбудителей ОКИ
9 возбудителей ОКИ входят в группу
бактерий с критическим уровнем
резистентности к антибиотикам
Род сальмонелл входит в группу высокой
резистентности (устойчив к F-хинолонам)
4. Таксономия сальмонелл
Семейство энтеробактерий –Enterobacteriacaeae
Триба Escherychicea
Род Salmonella
5. Триба ESCHERYCHICEA
EsherichiaShigella
Salmonella
Edwarsiella
Citrobacter
6. 4 типа патогенеза ОКИ
1. Холероподобный: холера и ЭТКП. ЭК неповреждаются, действует токсин.
Отсутствие воспаления
2. Межворсинчатый: ЭПКП. Слущивание
микроворсинок с повреждением ЭК.
Умеренное воспаление.
3. Инвазивный: шигеллы
4. Бактериемический: сальмонеллез
7. Род Salmonella
Впервые была выделена Т. Смитом в 1894году и названа в честь своего наставника
Даниэля Сальмона
Широко распространены у животных и
людей
Включает тифозную и нетифозную
группы
2016 г: включена в группу м/о
биологического оружия
8. США, штат Орегон, 2018
Религиозные фанатики добавилисальмонелл в куриный салат и
заразили более 1000 человек
1 млн случаев в год в мире,
летальность 25%
Наиболее опасны септические
формы
9. Конго, 2019 г
Вспышка сальмонеллеза в сентября-октября в септической форме
Вызвана панрезистентным штаммом
Salmonella typhimurium
Эти сальмонеллы потеряли жгутиковые
гены (снижается распознавание м/о
иммунными клетками)
Усилена адгезия к слизистой ЖКТ
10. Свойства сальмонелл
Подвижна за счетперитрихий (до 40
жгутиков)
Оксидазаотрицательна
Каталазаположительна
Имеет развитый
аппарат плазмид
11. Культуральные свойства
Мелкие колониидиаметром 2-4 мм
На средах Эндо и
Плоскирева
бесцветные
колонии
Факультативный
анаэроб
12. Элективная среда для сальмонелл
Висмут-сульфитагар
На зеленом фоне
агара черные
колонии
сальмонелл с
металлическим
блеском
13. Классификация Кауффмана-Уайта
По О-АГ разделяютсяна серологические
группы.
67 серогрупп
По Н-АГ – на серотипы
Более 2000 серотипов
Например, С(07)
14. Сальмонеллы
Пищевые =нетифозные
Вызывают
пищевой
сальмонеллез
Тифозные
Вызывают
тифы:
- Брюшной тиф
- Паратиф А
- Паратиф В
- Паратиф С
15. Пищевые сальмонеллы
Являются микрофлорой пресмыкающихсяНаиболее известные из более 2000 видов:
Salmonella tiphymurium, Salmonella
enteritidis, Salmonella enterica, Salm.
panama, Salm. salami, Salm. haifa, Salm.
london, Salm. montevideo, Salm. amsterdam
В конце XX века приобрели значение
внутригоспитальных патогенов
16. ВОЗ, 2017:
Сальмонеллы наращивают своюустойчивость к высоким
температурам
Например, Salmonella tiphymurium
выдерживает 80°С уже в течение 30
минут
17. Эпидемиология сальмонеллеза
Передается пищевым,водным и контактнобытовым путем
Госпитальный
сальмонеллез также и
респираторным путем
Госпитальные штаммы
имеют развитые Rплазмиды (сотни
плазмид с большим
количеством генов)
Чаще встречаются
в продуктах
животноводства, в
мясе птиц, яйцах
18. Патогенез пищевого сальмонеллеза
Попадает в тонкий кишечникПреодолевает эпителиальный барьер,
продвигаясь по межклеточному
пространству или внутри макрофагов.
В кровотоке появляются уже через 3-4
минуты после инфицирования
Бактериемия – обязательный элемент
патогенеза сальмонеллеза
19. Факторы патогенности
Жизнедеятельность сальмонелл вслизистой оболочке кишки
сопровождается продукцией энтерои цитотоксинов, а их разрушение —
выделением эндотоксинов, которые
и обусловливают развитие
диарейной, болевой и
интоксикационной симптоматики.
20. Бактериемия при сальмонеллезе
При локализованной форме поражаютсякишечник и региональные лимфоузлы
Однако происходит поступление
сальмонелл в кровь с эпизодической или
длительной бактериемией
При снижении иммунитета длительная
бактериемия сопровождает
генерализованную (тифоподобную) форму
пищевого сальмонеллеза
21. Сальмонелла внутри макрофага
В макрофагах сальмонеллы негибнут, перемещаясь с ними в кровь
и лимфу
Токсины
вызывают развитие
незавершенного
фагоцитоза
22. Лабораторная диагностика пищевого сальмонеллеза
1.2.
3.
4.
5.
Бактериологический метод. Трудно
выделить из испражнений, так как в
просвете кишечника сальмонеллы быстро
погибают
Серологическое исследование – РПГА,
реже ИФА
ПЦР-исследование кала
Эпидемиологическое расследование
ИХА – иммунохроматографический анализ
23. Профилактика пищевого сальмонеллеза
Санитарный контроль в пищевойпромышленности, общепите,
учреждениях питания
Соблюдение правил хранения
продуктов животного
происхождения
Внутригоспитальный контроль
24. Тифозная группа
Сальмонеллы, вызывающие брюшнойтиф и паратифы
Заболевание известно с глубокой
древности
Возбудитель открыт в 1880 году
несколькими исследователями
одновременно
Характерно «здоровое» носительство
25. «Тифозная Мэри»
Mary Mallon (1869-1938)Заразила более 100
человек, работая
поваром в
обеспеченных семьях
Увольнялась после
появления
заболевших
Мать Мэри в период
беременности болела
брюшным тифом
26. Тифозная группа сальмонелл
Размножаются в фагоцитах, блокируявыделение лизосомальных ферментов
Размножаются и циркулируют в крови в
течение 2-3 недель вследствие
ингибирования системы комплемента
Может сформироваться рецидивирующее
«здоровое» носительство
Vi-АГ (К-АГ) «вирулентный» является
ведущим антигеном в патогенезе
27. Vi -антиген
Действует на клетки организма,экспрессирующие полисахариды
Появляется сонливость,
недомогание, помрачение сознания
Неврологические осложнения
сопровождаются брадикардией и
снижением количества лейкоцитов
28. «Тиф»
Историческое название состояния созначительным повышением
температуры и спутанностью
сознания
Одновременно появляются
высыпания, отек языка («тифозный
язык»), брадикардия
29. РФ / СССР, 1970 – 6976 случ.
2007 г – вспышка среди военнослужащих,много субклинических форм
Завозные случаи: Азербайджан,
Таджикистан, Абхазия, Киргизия,
Узбекистан, Индия и др.
Возбудитель стал полирезистентным
MDR – устойчив к 4-м группам АБ
2016 г – 13 случаев в РФ
30. РФ, 2005-2019 гг
Зарегистрирован на 19 территориях РФ,в т.ч. в СФО и на ДВ – Томск, Кемерово,
Иркутск, Хабаровск, Еврейская АО
290 штаммов
47% - из крови, 50% - из фекалий
Биовар 1 (только 2 случая биовара 2)
73% резистентны к фторхинолонам
31. Брюшной тиф и паратифы
Salmonella typhi8 генотипов Salmonella typhi
Salmonella paratyphi A
Salmonella paratyphi B
Salmonella paratyphi C
32. Брюшной тиф и паратифы
Брюшной тиф –антропоноз, поражение
ЦНС
А –антропоноз без
поражения ЦНС
В – как пищевая форма,
антропозооноз
С – антропоноз, только
при ИДС
33. Эпидемиология
Единственным источникоминфекции при брюшном тифе и
паратифах А и С является человек –
носитель или больной
При паратифе В источником
инфекции также могут быть
цыплята и телята
34. Патогенез брюшного тифа
Длительнаябактериемия ведет к
поражению
внутренних органов
Повреждаются почки,
печень, костный мозг
Возможна перфорация
кишечника вследствие
некроза пейеровых
бляшек
35. Классическая лабораторная диагностика
1.2.
Бактериологическое исследование:
Кровь исследуется в период
лихорадки. Желчь, моча,
испражнения – после 2-3 недели.
Среды Эндо, Плоскирева, Левина.
Серологическое исследование:
Реакция Видаля (РА). На 2-3
неделе заболевания.
36. Современная диагностика
ИХА кала для экспресс-диагностикиПЦР-исследование сначала крови, в
более поздние сроки - желчи, кала,
мочи (обнаружение возбудителя,
прямая диагностика)
ИФА – обнаружение антител в крови
(косвенная диагностика)
37. Лечение и профилактика брюшного тифа и паратифов
Длительная АБ-терапия (весь периодлихорадки и дополнительно +10дн)
Используются левомицетин,
тетрациклин, фторхинолоны
Вакцинация контактных лиц (живая и
инактивированная вакцины)
Санитарно-противоэпидемические
мероприятия (проверка открытых
водоемов, питьевой воды и др.).
38. Инактивированная вакцина (с 2006 г, РФ)
Содержитинактивированный
капсульный Viантиген брюшнотифозной
сальмонеллы
с 3-х летнего
возраста
39. Вакцины против брюшного тифа (ВОЗ, 2018)
Конъюгированные(КВБТ)
С 6 мес 0,5 мл,
взрослым до 45
лет
В эндемичных
зонах
Неконъюгированные
Vi –полисахаридные
С 2-х лет
Ту21 – пероральная
вакцина
С 6 лет 3 дозы
40. 2018 г: первая конъюгированная вакцина против брюшного тифа
Возможно применение с 6-месячного возраста
Настороженность всех стран по
нарастанию резистентности микроба
11-20 млн случаев в год
128-161 тыс летальных случаев
41. Страны-риска (рекомендации)
За 2 недели до поездки в Индию,страны Юго-Восточной Азии,
Австралию, на Африканский
континент, в Центральную и Южную
Америку, страны Средней Азии
Летом при поездке в Таиланд, Лаос,
Кипр, Индию, Египет,
Доминиканскую республику

Медицина
Медицина








